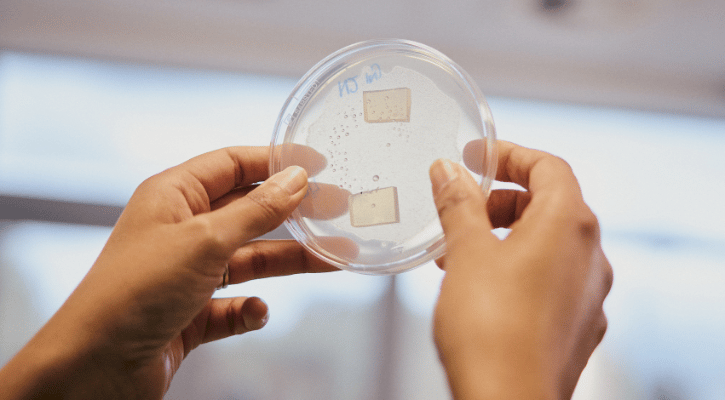

Fozia Saleem chats to Forum about life at the helm of Magnitude Biosciences – a North East early drug discovery business working to revolutionise healthy ageing and neurodegenerative disease research.
When Fozia Saleem moved to the North East in 2018, she didn’t expect it to become the backdrop for the most entrepreneurial chapter of her career so far. “We didn’t know how things were going to go,” she reflects. “But six months in, we were absolutely sold. It’s a lovely place to bring up kids – and the stereotype of Geordie folk being warm and welcoming is very true.”

Having spent over a decade in senior corporate roles, Fozia had reached a turning point. Post-COVID, she was juggling a busy career via Zoom, while raising a young family – and beginning to feel the spark fade. “I was very tired of being a Zoom bot,” she says. “Flexibility was great, especially with young children, but I’d lost my passion. I realised I’m a people person. I like connecting and I missed that.” Keen to re-ignite her purpose, she made a conscious decision to step outside her Londoncentric network and explore the business landscape in the North East. That’s when she began discovering the region’s thriving life sciences community. One introduction led to another, and before long, she met the team behind Magnitude Biosciences – a young but ambitious company based at NETPark in County Durham. “We were seven people on payroll when I joined,” she says. “Now we’re over 20 and growing.” Magnitude is a contract research organisation helping pharmaceutical and nutraceutical companies accelerate their innovation. By using C. elegans nematode worms – which share around 85% genetic homology with humans – the business is able to generate early-stage data on how drugs, supplements or disease models behave in a whole-organism system. It’s pioneering work that reduces time, cost and risk in clinical trials.
“It’s about helping our clients understand what their product does,” Fozia explains. “We’re not just testing shiny science for the sake of it – we’re guiding it towards an outcome that helps humankind.” Her drive for purposeful innovation has been the common thread in a career spanning corporate boardrooms and cutting-edge labs. A neurophysiologist by training, Fozia completed her PhD before landing a role on a competitive management programme in London. She rose quickly through the ranks, managing global launches, securing patents and leading product development across 26 markets. But it wasn’t enough. “I realised I was becoming a small cog in a very big machine,” she says. “I’d lost the fear. I needed something that would push me again.”
Relocating to the North East with her academic husband, Fozia stepped into the startup world and never looked back. The pair met while completing their PhDs, bonding over their shared love of science but soon taking divergent paths. “He stayed in academia, I moved into industry,” she explains. “I’ve always been an applied research person. For me, science is interesting, but I need to know what the destination is. I’m very outcome-focused, so academic science was never going to be the driver – it was always about what I could do with the science.” At Magnitude, those questions are front and centre. When she joined, the company was still deeply rooted in its academic origins – founded by two Durham University professors – but ready to scale.

Her mandate was clear: drive commercial growth, embed a business mindset, and prepare the company for acquisition. It wasn’t without its challenges. “I remember my first conversation with the chair. She asked how familiar I was with academics and I said, well, I’m married o one!” That understanding of both worlds has served her well. “Academic research is about curiosity – about what’s interesting,” she explains. “But in a business, you have to monetise innovation. You need a commercial outcome. So I brought in the culture shift. The science is still fascinating, but now we ask: how can we make it commercially viable?” That shift has paid off. The company’s patented WormGazer™ platform and VivoScanTM technology is delivering huge value in early-stage drug discovery, particularly in the complex field of neurodegenerative diseases. The impact is real – and global. Magnitude already operates in 12 countries, and Fozia’s vision is to push that even further. “We want to become the first company in the world to screen a million compounds using C. elegans and identify drugs that are successful in clinic,” she says. “That’s the ambition.”
When it comes to global opportunities in biosciences right now, Fozia believes they lie in early-stage drug discovery. “The number of blockbusters coming through the global pharmaceutical pipeline is shrinking,” she says. “It shocked a lot of us when Novo Nordisk – of Ozempic fame – made huge redundancies. They’re one of the richest, most successful pharma companies in the world, so it really shows how tough novel drug development has become.” The pressure, she says, is forcing companies to re-label existing drugs or explore new uses for old compounds – but that comes at the cost of innovation. “Drug discovery takes 10 to 15 years and costs billions – and by the time it reaches human trials, you might find you’ve been chasing a false positive. That’s where the opportunity is: reducing the cost and helping people fail fast, fail cheap.”
This year, she led the company’s biggest funding round to date – a near-£1 million raise that brings their total to just under £3 million. The investment will accelerate research into healthy ageing and support further international expansion. “It’s something I’m really proud of,” she says. “We raised in one of the toughest environments for startups especially outside the ‘Golden Triangle’ of London, Oxford and Cambridge.”
Being based in the North East has its pros and cons, she admits. “There’s a strong sense of community here – if I pick up the phone to another CEO at NETPark, I know I’ll get advice or a helpful steer. But you do have to shout louder to be heard.” Fozia is quick to acknowledge the geographic gap in access and opportunity. “When people think of biotech startups, they think of Cambridge or London,” she says. “We have to work harder to build those connections. A lot of our peers down south don’t need to travel as far or shout as loud.” Fundraising remains one of the toughest challenges for Magnitude. “I know a lot of friends who have businesses in the North East who’ve gone abroad,” Fozia says. “America has actually presented good opportunities. There’s a bit of a British culture of being risk averse, and the global climate isn’t helping. Fundraising is harder than it’s ever been.” With a Series A raise on the horizon, she's under no illusions about the scale of the task ahead. “We’ll probably have to go broader and wider. Learning from my peers, it’s definitely been easier to raise stateside.”
Despite this, she sees the North East’s supportive culture as a major advantage. “It’s a great ecosystem,” she adds. “And this is home now. I like to call myself an adopted Geordie,” she smiles. When asked how she measures success, Fozia doesn’t default to the usual metrics. “Yes, investors want to see a healthy bottom line. But for me, it’s about innovation with impact. If Magnitude can help develop therapeutics that improve the lives of people with neurodegenerative diseases, if we can help make clinical trials safer, faster, cheaper – that’s success.”
She’s just as proud of the culture she’s cultivated as the commercial milestones. “I’ve been able to build a team from scratch. I’ve trained people, brought in new skillsets, and created something special. That’s a real privilege.” Her leadership is rooted in authenticity, something she’s learned to lean into over the years. “I didn’t have role models that looked like me when I was growing up,” she says. “My dad came to the UK from Pakistan in the 60s. I was born in the North West in the 80s. Coming from a working-class migrant background, I wasn't surrounded by scientists or CEOs or even women that worked outside the family home. I’m proof that you can be what you can’t see, but you must have the perseverance and desire to succeed” That makes her current role even more meaningful. “If I can do my bit to show young girls – especially young brown girls – that this path is possible, that matters.”
Her advice to the next generation of entrepreneurs? Ask for help. “One of the best things I’ve learned since becoming CEO is that people are surprisingly willing to support you – you just have to ask. And don't be so afraid. Imposter syndrome can be a sign that you’re growing. If you’re in the room, you’re meant to be there. Take the seat at the table.”
As for what’s next, Fozia is focused on getting ready for the company’s next growth chapter. “Series A is coming. We want to build a commercial team, expand globally, and take the technologies we’ve developed over the last seven years into the next phase.” It’s a big ambition. But for someone who’s spent her career making science count – and isn’t afraid of a little fear – it's certainly within reach.








